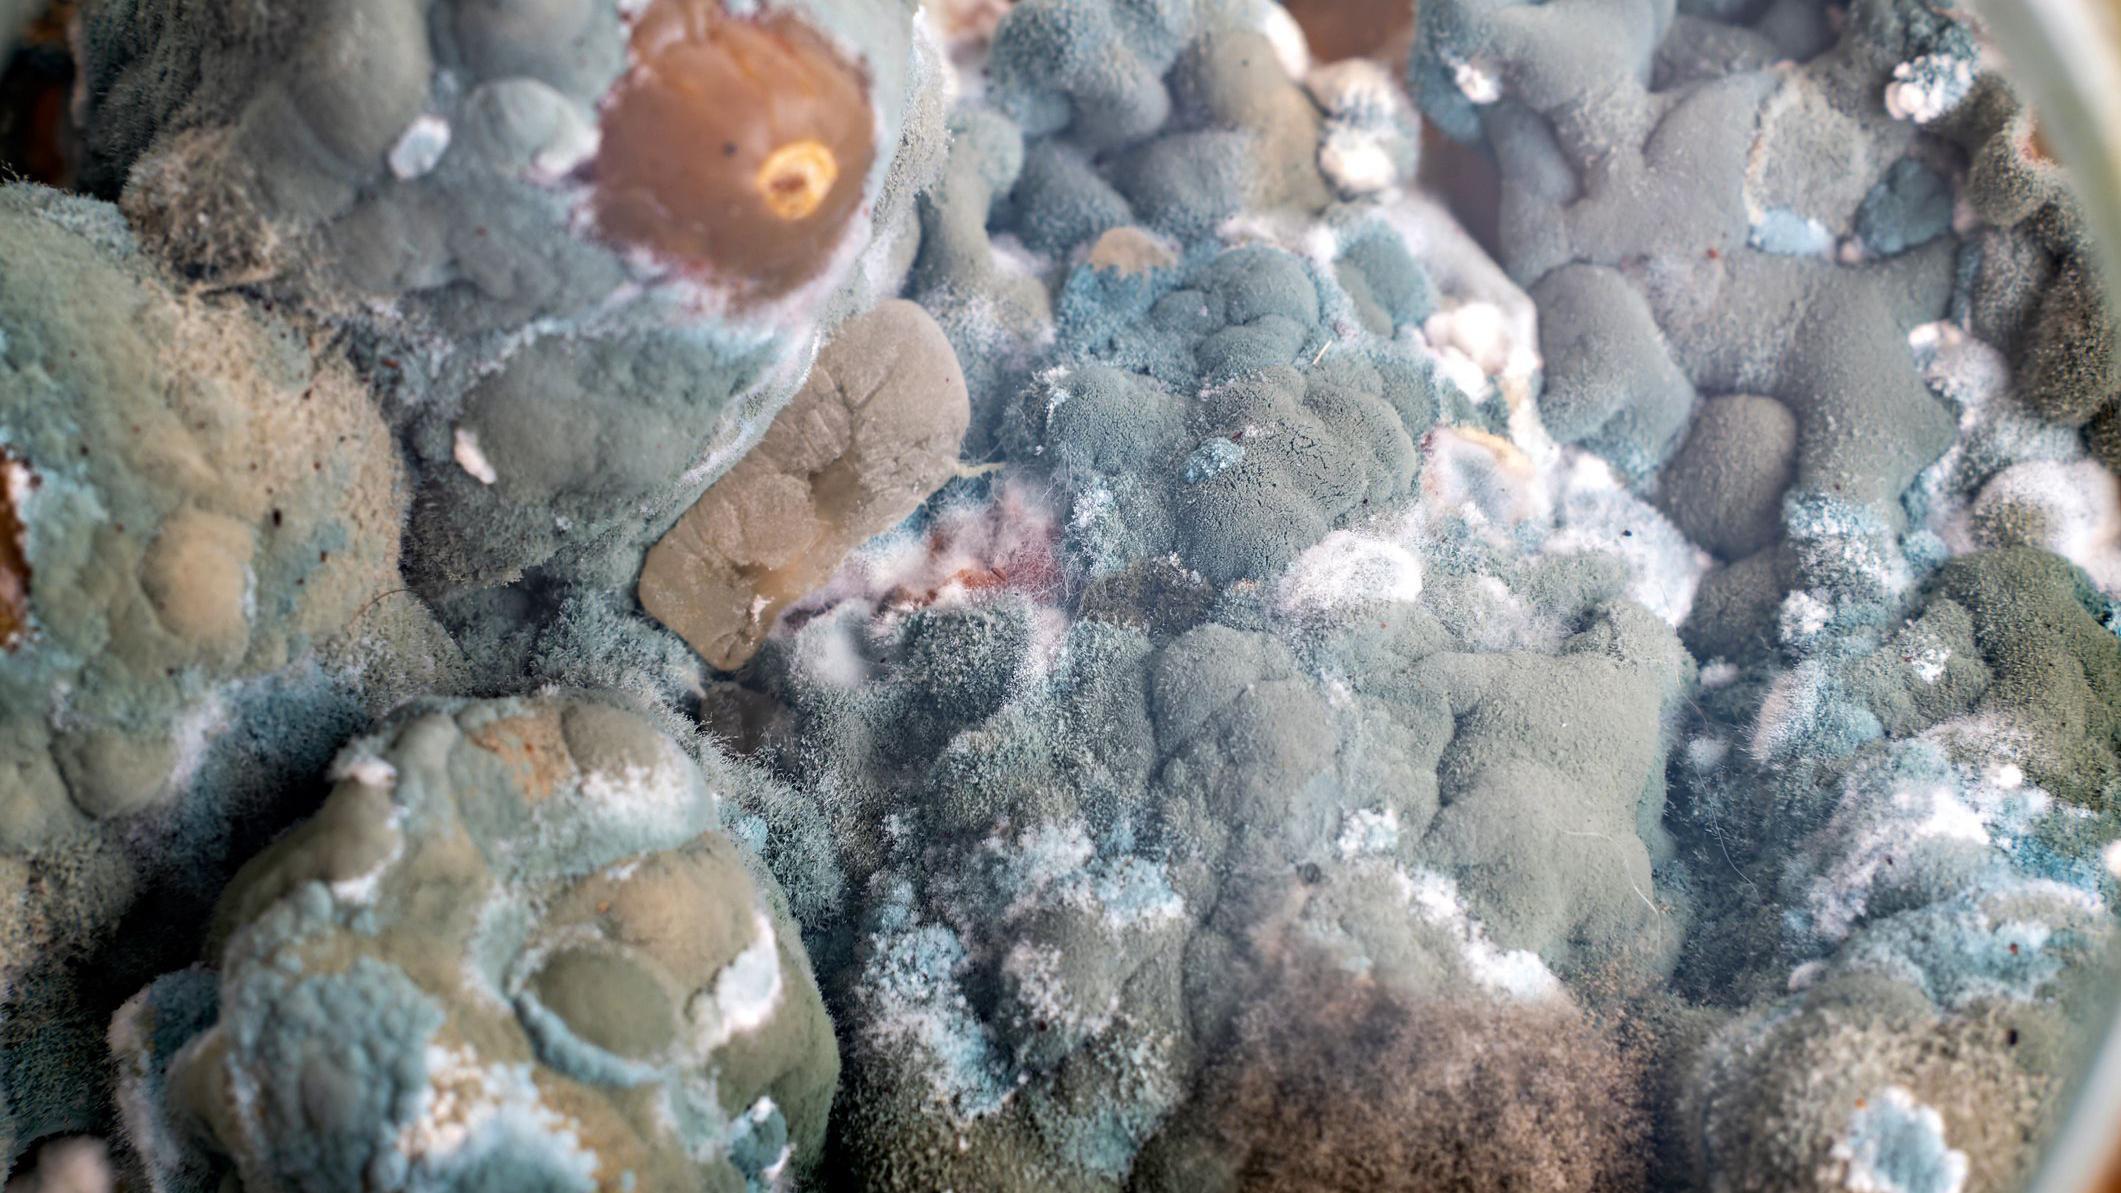
Vista próxima de mofo

Em maio de 1997, Nelli Zhdanova entrou em um dos lugares mais radioativos do mundo: as ruínas abandonadas da central nuclear de Chernobyl, na Ucrânia. E descobriu que não estava sozinha.
No teto, nas paredes e no interior dos condutores metálicos que protegem os cabos elétricos, o mofo preto havia se instalado em um local antes considerado prejudicial para a vida.
Na ausência de seres humanos, ressurgiram os lobos e javalis nos campos e no bosque em torno da usina nuclear.
Mas, ainda hoje, existem ali zonas específicas com níveis alarmantes de radiação, devido ao material expelido pelo reator ao explodir, em 1986.
Formado por diversos tipos de fungos, o mofo parecia fazer algo extraordinário. Ele não se desenvolveu ali simplesmente porque os trabalhadores da usina foram embora.
Na verdade, Zhdanova já havia descoberto, em estudos anteriores do solo em volta de Chernobyl, a existência de fungos crescendo em direção às partículas radioativas que cobrem aquela região.
Agora, ela descobriu que os fungos chegaram à fonte original da radiação: as salas no interior do edifício do reator que explodiu.
Cada estudo levava Zhdanova a se aproximar mais e mais da radiação nociva. Mas seu trabalho revolucionou nossas ideias sobre como a radiação afeta a vida na Terra.
Agora, sua descoberta oferece a esperança de limpar locais radioativos e até a possibilidade de proteger os astronautas contra a radiação durante suas viagens espaciais.
O acidente que marcou época
Onze anos antes da visita de Zhdanova, um teste de segurança de rotina no reator 4 da usina nuclear de Chernobyl se transformou rapidamente no pior acidente nuclear da história.
Uma série de erros de projeto e de operação do reator provocou uma enorme explosão, na madrugada de 26 de abril de 1986. O resultado foi uma única liberação massiva de radionuclídeos.
O iodo radioativo foi uma das principais causas de morte nos primeiros dias e semanas após o acidente e, mais tarde, do aumento de casos de câncer.
Em uma tentativa de reduzir o risco de envenenamento por radiação e complicações de saúde a longo prazo, foi estabelecida uma zona de exclusão de 30 km, também conhecida como “zona de isolamento“, para manter as pessoas afastadas dos restos radioativos mais perigosos do reator 4.
Mas, enquanto os seres humanos eram mantidos afastados, o mofo negro de Zhdanova colonizava lentamente a região.

A pesquisa de Zhdanova indicou que, como as plantas que procuram a luz solar, as hifas fúngicas do mofo preto pareciam ser atraídas pela radiação ionizante.
Mas o “radiotropismo”, como chama Zhdanova, era um paradoxo. A radiação ionizante costuma ser muito mais potente que a luz solar. Sua descarga de partículas radioativas destrói o DNA e as proteínas, como balas perfurando carne viva.
O dano causado pode desencadear mutações nocivas, destruir células e matar organismos.
Além dos fungos aparentemente radiotrópicos, os estudos de Zhdanova encontraram 36 outras espécies de fungos comuns, mas com relação distante, crescendo em torno de Chernobyl.
Nas duas décadas que se seguiram, seu trabalho pioneiro para identificar os fungos radiotrópicos chegaria até muito além da Ucrânia. Ele contribuiria para o conhecimento sobre uma possível nova base para a vida na Terra, que se desenvolveria graças à radiação e não à luz solar.
Os estudos também levariam os cientistas da Nasa, a agência espacial americana, a considerar a possibilidade de cercar seus astronautas com paredes de fungos, como forma duradoura de suporte vital.
A melanina
No centro desta história, encontra-se um pigmento presente em larga escala na vida terrestre: a melanina.
Esta molécula pode variar do preto até o marrom avermelhado. Ela determina as diferentes cores de pele e de cabelo das pessoas.
Mas a melanina também é o motivo que leva as diferentes espécies de mofo que crescem em Chernobyl a terem coloração preta. Suas paredes celulares estavam repletas de melanina.
Assim como a pele mais escura protege nossas células contra a radiação ultravioleta (UV), Zhdanova suspeitou que a melanina dos fungos age como escudo contra a radiação ionizante.

Os fungos não foram os únicos a fazer uso das propriedades protetoras da melanina.
Nos tanques em torno de Chernobyl, as rãs com maior concentração de melanina nas células e, portanto, de cor mais escura, conseguiram sobreviver e se reproduzir melhor, escurecendo paulatinamente a população local de rãs que vivia por ali.
Durante uma guerra, um escudo pode proteger os soldados das flechas ao desviá-las do seu corpo. Mas a melanina não funciona desta forma.
Ela não é uma superfície dura, nem lisa. A radiação, seja ela UV ou na forma de partículas radioativas, é absorvida pela sua estrutura desordenada e sua energia se dissipa, em vez de ser desviada.
A melanina também é antioxidante, ou seja, é uma molécula que pode transformar os íons reativos produzidos pela radiação em matéria biológica e devolvê-los a um estado estável.
Radiação como alimento
Em 2007, a cientista nuclear Ekaterina Dadachova, da Faculdade de Medicina Albert Einstein de Nova York, nos Estados Unidos, colaborou com o trabalho de Zhdanova sobre os fungos de Chernobyl.
Ela revelou que seu crescimento não era apenas direcional (radiotrópico), mas também aumentava na presença de radiação.
Dadachova descobriu que os fungos melanizados, da mesma forma que os do reator de Chernobyl, crescem com rapidez 10% maior na presença de césio radioativo, em comparação com os mesmos fungos cultivados sem radiação.
A cientista e sua equipe também concluíram que os fungos melanizados irradiados aparentemente usam a energia para impulsionar seu metabolismo. Em outras palavras, eles a empregam para crescer.

Zhdanova já havia indicado que estes fungos talvez usassem a energia da radiação. Agora, a pesquisa de Dadachova aparentemente se baseava nesta ideia.
Os fungos não crescem apenas em direção à radiação para obter calor ou alguma reação desconhecida entre a radiação e seu entorno, como Zhdanova havia sugerido.
Dadachova acredita que os fungos se alimentem ativamente da energia da radiação. Ela chamou este processo de “radiossíntese” e a melanina foi fundamental para sua teoria.
“A energia da radiação ionizante é cerca de um milhão de vezes maior que a energia da luz branca, utilizada na fotossíntese”, afirma a cientista.
“Portanto, é necessário um transdutor de energia muito poderoso, o que acreditamos que a melanina seja capaz de fazer: realizar a transdução da radiação ionizante, gerando níveis de energia que possam ser utilizados.”
A radiossíntese continua sendo apenas uma teoria. Ela só poderá ser demonstrada se for descoberto o mecanismo preciso existente entre a melanina e o metabolismo.
Os cientistas precisariam encontrar o receptor exato, ou um trecho específico da intricada estrutura da melanina, que participa da transformação da radiação em energia para crescimento.
Radiação cósmica
Nos últimos anos, Dadachova e seus colegas começaram a identificar alguns dos processos e proteínas que poderiam explicar o aumento do crescimento dos fungos com a radiação ionizante.
Nem todos os fungos melanizados demonstram tendência ao radiotropismo e crescimento positivo na presença de radiação.
Um estudo de 2006, realizado por Zhdanova e seus colegas, descobriu que apenas nove das 47 espécies de fungos melanizados coletadas em Chernobyl cresceram em direção a uma fonte de césio radioativo (césio-137).
Da mesma forma, em 2022, cientistas dos Laboratórios Nacionais Sandía, no Estado americano do Novo México, não encontraram diferenças de crescimento quando duas espécies de fungos (uma melanizada e outra não) foram expostas à radiação UV e césio-137.
Mas, naquele mesmo ano, a mesma tendência de crescimento fúngico mediante exposição à radiação foi detectada no espaço.
Diferentemente da desintegração radioativa detectada em Chernobyl, a chamada radiação cósmica galáctica é uma tempestade invisível de prótons carregados. Cada um deles viaja pelo universo quase à velocidade da luz.
Originada na explosão de estrelas fora do nosso sistema solar, ela chega a atravessar o chumbo sem grandes dificuldades.
Na Terra, nossa atmosfera nos protege dela em grande parte. Mas, para os astronautas que viajam para o espaço profundo, a radiação cósmica galáctica foi descrita como “o maior perigo” existente para a saúde humana.
Nem mesmo essa radiação representou problema para as amostras de Cladosporium sphaerospermum, a mesma cepa encontrada por Zhdanova crescendo em Chernobyl, segundo um estudo que enviou esses fungos para a Estação Espacial Internacional em dezembro de 2018.
“O que demonstramos é que elas crescem melhor no espaço”, afirma Nils Averesch, bioquímico da Universidade da Flórida, nos Estados Unidos, um dos autores do estudo.

Em comparação com as amostras de controle na Terra, os pesquisadores descobriram que os fungos expostos à radiação cósmica galáctica por 26 dias cresceram, em média, 1,21 vez mais rápido.
Ainda assim, Averesch não está convencido de que isso ocorra porque C. sphaerospermum faria uso da radiação no espaço. Ele defende que o aumento dos níveis de crescimento também poderia ocorrer devido à gravidade zero, outro fator que os fungos não vivenciaram na Terra.
Averesch está realizando experimentos com uma máquina de posicionamento aleatório, que simula a gravidade zero aqui na Terra para analisar estas duas possibilidades.
Mas Averesch e seus colegas também testaram o potencial de proteção da melanina em C. sphaerospermum, colocando um sensor embaixo de uma amostra de fungos a bordo da Estação Espacial Internacional.
Em comparação com as amostras sem fungos, a quantidade de radiação bloqueada aumentou à medida que os fungos cresciam e até uma mancha de mofo em uma placa de Petri parecia ser um escudo eficaz.
“Considerando a camada comparativamente fina de biomassa, isso pode indicar grande capacidade de C. sphaerospermum de absorver a radiação especial no espectro medido”, segundo os pesquisadores.
Averesch afirma que ainda é possível que os aparentes benefícios de radioproteção dos fungos se devam a outros componentes da vida biológica, não à melanina.
A água, por exemplo, é uma molécula com grande número de prótons na sua estrutura (oito no oxigênio e um em cada hidrogênio). Ela é uma das melhores formas de se proteger contra os prótons que se deslocam pelo espaço — o equivalente astrobiológico a combater fogo com fogo.
Ainda assim, as descobertas trouxeram perspectivas interessantes para solucionar o problema da vida no espaço.
A China e os Estados Unidos pretendem construir uma base na Lua nas próximas décadas. Já a SpaceX, com sede no Texas (EUA), pretende lançar sua primeira missão para Marte no final de 2026, com seres humanos chegando ao planeta vermelho três a cinco anos depois.
As pessoas que morarem nessas bases precisarão ser protegidas contra a radiação cósmica. Mas usar água ou polietileno como um casulo radioprotetor para essas bases pode ser pesado demais para a decolagem.
O metal e o vidro apresentam um problema similar.
A astrobióloga Lynn J. Rothschild, do Centro de Pesquisa Ames da Nasa, comparou o transporte desses materiais, para a construção de bases no espaço, com uma tartaruga carregando sua carapaça para toda parte.
“É um plano confiável, mas com alto custo energético”, declarou ela em 2020, em um comunicado da Nasa.
Sua pesquisa gerou móveis e paredes à base de fungos, que poderão ser cultivados na Lua ou em Marte.
Essa “micoarquitetura” não só reduziria os custos do lançamento, mas, se as conclusões de Dadachova e Averesch estiverem corretas, também poderá ser utilizada para formar um escudo contra a radiação — uma barreira autorregenerativa entre os seres humanos que viajam para o espaço e a tempestade de radiação cósmica galáctica no lado exterior.
Assim como colonizaram um mundo abandonado em Chernobyl, talvez algum dia esses mesmos fungos pretos possam proteger nossos primeiros passos em novos mundos, localizados em outras partes do Sistema Solar.
Alex Riley é um escritor de ciências premiado e autor do livro Super Natural: Como a Vida se Desenvolve em Lugares Impossíveis (em inglês). Ele está disponível no Instagram.
Leia a versão original desta reportagem (em inglês) no site BBC Innovation.
